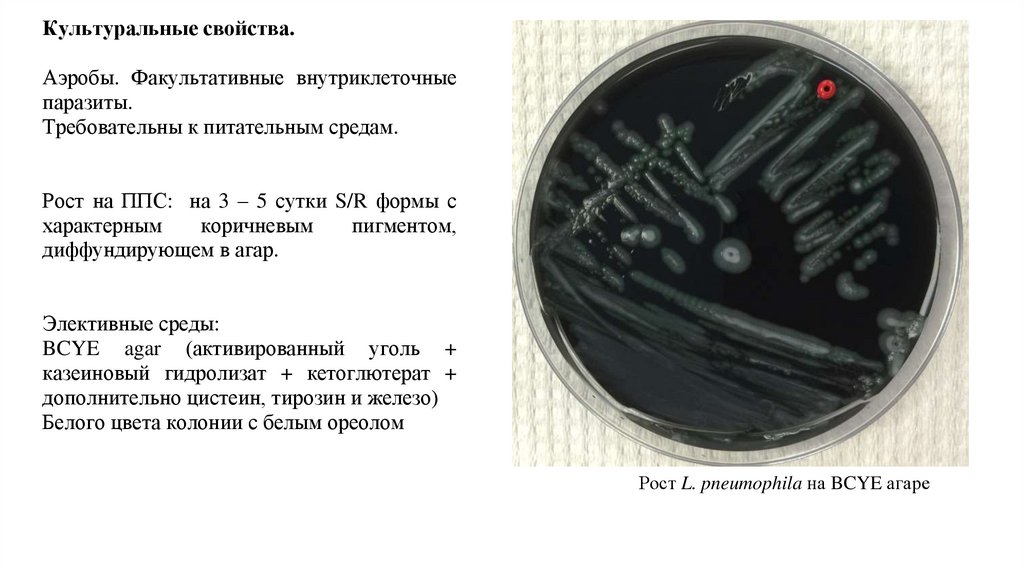

Похожие презентации:
Легионеллы
1.
Легионеллы2.
L. pneumophila3.
Морфология.Гр – палочки, встречаются нитевидные
формы до 20 мкм.
Подвижны (амфитрихи или монотрихи)
Капсулу не образуют.
Спор не образуют.
При
микроскопии
наблюдаются
множественные липидные вакуоли.
4.
Культуральные свойства.Аэробы. Факультативные внутриклеточные
паразиты.
Требовательны к питательным средам.
Рост на ППС: на 3 – 5 сутки S/R формы с
характерным
коричневым
пигментом,
диффундирующем в агар.
Элективные среды:
BCYE agar (активированный уголь +
казеиновый гидролизат + кетоглютерат +
дополнительно цистеин, тирозин и железо)
Белого цвета колонии с белым ореолом
Рост L. pneumophila на BCYE агаре
5.
Возможна культивация в желточном мешке РКЭ,Так же культивируют на культуре клеток – дёгочный фибробласт человека.
6.
Биохимическая активность.Биохимически малоактивны. Практически не ферментируют углеводы. В качестве
источника углевода получают при ферментации аминокислот и белков.
7.
АГ - структура.Антигенная структура достаточно сложная, основными антигенами являются типо- и
группоспецифические. По антигенам у легионелл выделяют не менее 8 серогрупп. Имеется
антигенное родство между L. pneumophila и Chlamydia psittaci
8.
Факторы патогенности.9.
Патогенез.10.
Клиническая картина.Ярко выраженная сезонность заболеваемости лето
– осень. Особенно частые вспшки в летний
период.
ИП: От 2х до 10 суток
Заболевание может протекать по разному. От
гриппоподобного течения до тяжелой крупозной
пневмонии с нарушением сознания, диареей без
кровяных включений, а также протеинурией,
микрогематурией.
Лихорадка Понтиак – гриппоподобное
заболевание без развития пневмонии.
Лихорадка форта Брагг - лихорадка с
температурой от 38 до 38,5, сопровождающуюся
головной болью и полиморфной сыпью на коже.
Экзантема, как правило, крупнопятнистая,
кореподобная и петехиальная без шелушения. При
этом локализация может быть различной. Болезнь
продолжается от трёх до семи дней с
благоприятным течением.
11.
Диагностика.Прямая микроскопия мокроты. РИФ.
Выявление антигенов в исследуемом материале
при помощи ИФА и РИА.
ПЦР.
12.
Лечение.Применяют антибиотики: эритромицин
сочетании с рифампицином.
Могут применяться фторхинолоны
+ симптоматическая терапия
Профилактика.
в

Биология
Биология








